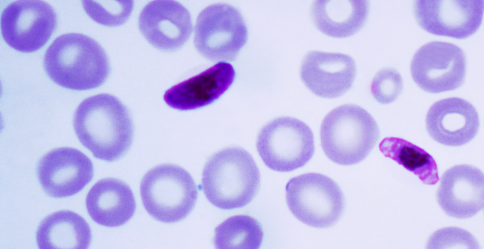

PeptideAtlas: Home Overview Contacts Publications Software Database Schema Feedback Funding FAQ
Related: SRMAtlas PASSEL SWATHAtlas
Spectral Libs: Libraries + Info SpectraST Search
Glossary/Terms: Atlas nomenclature Protein ID terms
LOG IN


PeptideAtlas is a multi-organism, publicly accessible compendium of peptides identified in a large set of tandem mass spectrometry proteomics experiments. More...

| 2026-01-14 | The Human All build, with 1,246 datasets and a total of 1.75 billion PSMs, and mapping to UniProtKB 2025_11 and Ensembl 115, has been released. |
| 2025-09-20 | The E coli 2024-11 build has been publicly released. |
| 2025-09-03 | The Human Plasma 2025-08 build has been publicly released. |
| 2025-06-09 | The Toxoplasma Phosphoproteome 2025-05 build has been publicly released. |
| 2025-04-22 | The Rice 2025-03 build has been publicly released. |
| 2025-03-13 | The Human SUMOylation Proteome 2025-02 build has been publicly released. |
| 2025-02-07 | The Candida albicans 2024-03 build has been publicly released. |
| 2025-02-04 | The Human All build, with 806 datasets and a total of 1.11 billion PSMs, and mapping to the latest UniProtKB (2024_06) and Ensembl 113, has been released. |
| 2025-01-15 | The Trypanosoma brucei Phosphoproteome build, with a total of 65,056 disinct phosphopeptides has been released. |
| 2025-01-15 | The Maize Phosphoproteome build, with a total of 57,276 disinct phosphopeptides has been released. |
| 2024-10-31 | The Yeast Phosphoproteome build, with a total of 549,527 disinct phosphopeptides has been released. |
| 2024-02-07 | The Human All build, with 213 new datasets and a total of 868 million PSMs, and mapping to the latest UniProtKB and Ensembl 110, has been released. |
| 2023-11-06 | The Plasmodium falciparum Phosphoproteome 2023-10 build has been publicly released. |
| 2023-10-31 | The Maize 2023-09 build has been publicly released. |
| 2023-10-31 | The Rice 2022-12 build has been publicly released. |
| 2023-10-27 | The Human HLA 2023-11 build, created from the subset of all human proteomics datasets that are derived from samples enriched in MHC class I- and class II-bound peptides, has been publicly released. |
| 2023-10-26 | The Arabidopsis thaliana 2023-10 build has been publicly released. |
| 2023-05-19 | The Human Plasma 2023-04 as well as the Human Plasma Extracellular Vesicle 2023-04 builds have been publicly released. |
| 2023-01-21 | The Human All build, with 75 new datasets and a total of 750 million PSMs, and mapping to the latest UniProtKB and Ensembl 107, has been released. |
| 2023-01-05 | The Arabidopsis thaliana PeptideAtlas 2022-06 build has been publicly released. |
| 2022-08-25 | The latest Yeast build, with a total of almost 61 million PSMs has been released. |
| 2022-08-25 | The Rice Phosphoproteome build, with a total of 14,013 disinct phosphopeptides has been released. |
| 2022-08-25 | The Human Urine build, with a total of 6.3 million PSMs has been released. |
| 2022-01-06 | The Human All build, with 124 new datasets and a total of 679 million PSMs, and mapping to the latest UniProtKB and Ensembl 105, has been released. |
| 2021-12-22 | The Labeo rohita PeptideAtlas 2020-07 build has been publicly released. A preprint describing the methods and results can be accessed here, DOI: 10.21203/rs.3.rs-397364/v1 |
| 2021-08-15 | The Human Plasma PeptideAtlas 2021-07 as well as the Human Plasma Extracellular Vesicle PeptideAtlas 2021-06 builds have been publicly released. A preprint describing the methods and results from these builds will be available soon. |
| 2021-04-24 | The Arabidopsis thaliana PeptideAtlas 2021-03 build has been publicly released. A publication describing the methods and results from this build has been accepted in The Plant Cell . |
| 2021-03-15 | Pseudomonas aeruginosa PeptideAtlas is published. The build is available to search. |
| 2021-02-11 | New Human All build is now available to search. |
| 2020-06-01 | SARS-CoV-2 build is available to search |
| 2020-01-22 | First B. burgdorferi build is available to search |
| 2020-01-24 | New Human All build is now available to search. |
| 2019-06-01 | S. pneumoniae D39 and S. pneumoniae TIGR builds are available to search. The datasets for the builds are from the publication, In vivo proteomics identifies the competence regulon and AliB oligopeptide transporter as pathogenic factors in pneumococcal meningitis |
| 2019-01-23 | New Human All build is now available to search. |
| 2018-09-12 | The ProteoMapper peptide mapping tool is now online. |
| 2018-01-05 | New Human All build is now available to search. |
| 2017-05-16 | Human Plasma 2017-04 build is now available. |
| 2017-02-01 | Human Testis build is now available. |
| 2017-01-06 | New Human All and Human Phosphoproteome builds are now available to search. |
| 2016-02-01 | New Human All build is now available. |
| 2015-09-28 | A new Human Plasma build is now available to search. |
| 2015-09-24 | A new Human Phosphoproteome build is now available to search. |
| 2015-06-15 | A new Human Phosphoproteome build is now available to search. The build is an update of last build in which all non-phosphorylated peptides have been filtered out. |
| 2015-05-19 | A new Pig build is now available to search. |
| 2015-03-05 | The Human build is now available to search. |
| 2015-01-15 | The Human PeptideAtlas Build is now available as a custom trac at the UCSC Human Genome Browser. |
| 2014-07-31 | New Human build is now available to search. |
| 2014-04-25 | First zebrafish build is now available to search. |
| 2014-01-23 | The paper, The Equine PeptideAtlas - a resource for developing proteomics-based veterinary research, appears online. |
| 2013-12-06 | First Rat build is now available to search. |
| 2013-09-25 | The HoneyBee build has been updated and is now available to search. |
| 2013-09-19 | New human urine and human kidney builds are now publicly available. |
| 2013-09-10 | The manuscript, The Equine PeptideAtlas - a resource for developing proteomics-based veterinary diagnostics, has been submitted. The related build, Horse 2013-04 are now publicly available. |
| 2013-08-20 | The first Human Liver build is publicly available now. |
| 2013-08-15 | We researched all human datasets using new search database, which includes CompleteProteome and varsplic proteins. A list of new human builds based on new search results have been made available, such as Human 2013-08 and Human Others 2013-08. |
| 2013-06-13 | First two C. albicans builds, C. albicans 2011-12 and C. albicans 2012-01 PTM are now publicly available. A paper about both builds has been submitted to the special issue on microbial proteomics of the Journal of Proteomics. |
| 2013-05-01 | The paper, N-Glycoprotein SRMAtlas: A RESOURCE OF MASS SPECTROMETRIC ASSAYS FOR N-GLYCOSITES ENABLING CONSISTENT AND MULTIPLEXED PROTEIN QUANTIFICATION FOR CLINICAL APPLICATIONS., appears in Mol Cell Proteomics (10.1074/mcp.O112.026617). Two related builds Human Glyco Synthetic Peptides 2012-07 and Mouse Glyco Synthetic Peptides 2012-07 are now publicly available. |
| 2013-04-25 | The manuscript, The Mtb Proteome Library: Quantitative Assays for the Complete Proteome of Mycobacterium tuberculosis, got officially accepted by Cell Host & Microbe. Two related builds M. tuberculosis 2013-05 and M. tuberculosis Light DirtyPeptide 2013-05 are now publicly available. |
| 2013-04-10 | S. pombe 2012-08 PeptideAtlas build are now available to search. The paper Extensive Mass Spectrometry-Based Analysis of the Fission Yeast Proteome: The S. pombe PeptideAtlas. , appears in Mol Cell Proteomics (mcp.M112.023754). |
| 2013-04-04 | New Human and Yeast builds are now publicly available. The human build includes support for sequence variations from UniProt. |
| 2013-01-16 | P. falciparum and P. yoelii PeptideAtlas are now available. The paper Total and Putative Surface Proteomics of Malaria Parasite Salivary Gland Sporozoites, appears in Mol Cell Proteomics (mcp.M112.024505). |
| 2012-11-21 | New Human PeptideAtlas is now available to search |
| 2012-07-31 | New Human PeptideAtlas is now available to search |
| 2012-06-22 | The latest versions of spectrum libraries from NIST are now available at the PeptideAtlas Spectrum Library Central Page. |
| 2012-04-27 | First Cow PeptideAtlas is now available to search. All data including any formats can be download from our repository site. |
| 2012-03-28 | New Human PeptideAtlas is now available to search. 5 cell line data sets from recent publications, Nagaraj et al. 2011, Beck et al. 2011, Munoz et al. 2011, Sharma et al. 2011, and Geiger et al. 2012 have been added to this build. For the older data sets, only the experiments searched with decoy database are included in order to get a good estimate of decoy FDR. Those not searched with decoy database will be researched, and add to build later. |
| 2011-09-27 | The PeptideAtlas SRM Experiment Library ( PASSEL) is now available for general use. Thus far it contains only a few public experiments, but several datasets are under review and will become public upon acceptance. We encourage submissions of SRM experiment datasets. |
| 2011-09-13 | Human Brain PeptideAtlas is now available to search. Raw data is available to download from PeptideAtlas repository. The build is available to download. |
| 2011-06-16 | A set of 1929 human plasma proteins at FDR 1% in PeptideAtlas was published June 1. This is by far the largest plasma set at this confidence level, combining 91 contributed experiments. |
| 2011-05-24 | PeptideAtlas Chromosome Explorer (PACE) provides a high-level visualization of the Human PeptideAtlas Build, displayed by chromosome. |
| 2011-05-14 | First HoneyBee PeptideAtlas is now available to search. The paper is submitted to the BioMed Central and under review. Raw data is avaiable to download from PeptideAtlas repository. The PeptideAtlas build for Honeybee is available to download. |
| 2010-08 | Graphical depiction of chromosome coverage for human builds available. Use Browse Proteins and specify a single chromosome. |
| 2010-07 | The latest versions of Human, Mouse, Drosophila, and Celegans builds are now available at the PeptideAtlas. Version 57 of the EnsEMBL is used for the peptides mapping in all of the new builds. |
| 2010-06 | The latest versions of spectrum libraries from NIST are now available at the PeptideAtlas Spectrum Library Central Page. |
| 2010-03 | Members of the PeptideAtlas team have recently published mspecLINE, a web application that allows researchers to explore relationships between human diseases and the observed proteome. |
| 2010-02 | For the first time, a Mouse PeptideAtlas build, based on 64 samples from a variety of tissues and subcellular compartments, is available to search. |
If you use PeptideAtlas in your research, please cite us:
General purpose citation: Desiere et al., "The PeptideAtlas Project", Nucleic Acids Research, 2006, 34, D655-D658 - [PDF]The PeptideAtlas project acknowledges the various funding sources that have made it possible to develop and maintain this community resource.